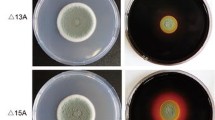

Abstract
The bioactivity of swollenin is beneficial to cellulose decomposition by cellulase despite the lack of hydrolytic activity itself. In order to improve the productivity of swollenin, the effects of culture conditions on the expression level in recombinant Aspergillus oryzae were investigated systematically. With regard to the bioactivity of swollenin, glycerin and peanut meal were the optimal carbon or nitrogen source, respectively. The highest level production of swollenin (50 mg L−1) was attained after 88 h cultivation with the initial pH of 5.6 in the culture medium. Then the soluble swollenin was effectively purified from the cultural supernatant by ammonium sulfate precipitation and cationic exchange chromatography with recovery yield of 53.2%. The purified swollenin was fully bioactive due to its strong synergistic activity with cellulose.
Similar content being viewed by others
Explore related subjects
Discover the latest articles, news and stories from top researchers in related subjects.Avoid common mistakes on your manuscript.
Introduction
Expansins are a group of plant cell wall proteins regulating cell wall extensibility during cell expansion [1, 2]. Expansins are thought to disrupt hydrogen bonding between cellulose microfibrils or between cellulose and other cell wall polysaccharides without hydrolyzing them [3, 4]. Based on structure difference, expansins are divided into four subfamilies: α-, β-, γ-, and δ-expansins [5]. Swollenin is a novel fungal protein with significant sequence similarity to plant expansins, which was firstly isolated from the Trichoderma reesei in 1992 [6]. In the structure of swollenin, the expansin-like domain was connected by a linker region to a cellulose binding domain, which serves to anchor the swollenin to the insoluble substrate. Researches show that swollenin can act on cellulose materials and cause a partial damage, loose structure, and reduction of intensity similar to that caused by ultrasound treatment, while do not produce reducing sugar [6].
Cellulose is the most abundant forms of carbohydrate in nature and represents potential feedstocks for the production of chemicals to replace petroleum [7]. On a commercial scale, the conversion of cellulosic biomass requires the use of cellulase that makes the process more costly [7–9]. Accordingly, it is essential to develop a more efficient enzymatic process for the hydrolysis of cellulosic biomass. The activity of swollenin is very helpful to cellulose decomposition by cellulase despite the lack of hydrolytic activity itself. Thus, the swollenin and cellulase are supposed to synergistically convert cellulose into glucose and some other reducing sugars, which can be effectively utilized to produce a variety of biorefinery products, such as butyric acid [10, 11] and poly-γ-glutamic acid [12, 13], etc. However, the yield of swollenin in T. reesei is too low to meet the demand in industrial applications. It will be promising to produce swollenin effectively and efficiently by using recombinant techniques.
The swollenin gene has been successfully cloned and expressed in yeast and Aspergillus niger var. awamori [6]. Though swollenin was expressed as soluble form in yeast, the expression level was low (25 μg L−1), and the expression level in A. niger var. awamori had not been reported. Most of the previous works [6, 14, 15] mainly focused on the investigation of swollenin activity, little information about the effects of medium composition and expression conditions on the productivity of swollenin protein was available in the literature. In the present work, we focused on the investigation of the effects of different medium composition and expression conditions on the production of swollenin protein in recombinant Aspergillus oryzae system. And the swollenin protein was purified from the cultural supernatant and proved to be bioactive by the determination of its synergistic activity with cellulase. This study will be helpful to develop an efficient process to produce bioactive swollenin at the large scale.
Materials and Methods
Strain and Medium
The recombinant A. oryzae ZD-10 was preserved in our laboratory and used to produce swollenin in the following optimization experiments. The swollenin gene was expressed under control of pNo-8142 promoter of plasmid pNAN8142 and the A. oryzae niaD300 was used as a recipient strain for A. oryzae ZD-10 construction. The compositions of medium used in slant culture and expression studies in this work are as follows. Chemical-defined medium (w/v): 2% glucose, 0.3% NaNO3, 0.2% KCl, 0.1% KH2PO4, 0.05% MgSO4·7H2O, 0.002% FeSO4·7H2O, 0.0015% methionine, 1.5% agar. DPY medium (pH 5.6): 2% dextrin, 1% polypeptone, 0.5% yeast extract, 0.5% KH2PO4, 0.05% MgSO4·7H 2O.
Expression and Analysis of Proteins
The strain on slant medium was incubated at 28°C for 7 days, and fermentation were carried out by inoculating 50 mL medium in 250 mL flask and incubating in an orbital shaker at 30°C and 250 rpm for 4 days. Different kinds of carbon sources and nitrogen sources were investigated individually to determine their effect on swollenin activity. The expression time and the pH value were also assessed as optimization conditions. Protein expression was analyzed by sodium dodecyl sulfate polyacrylamide gel electrophoresis (SDS-PAGE) [16] method (12% gel). The protein bands were visualized by Coomassie brilliant blue R250. Protein quantification was done using the Quantity One software (Bio-Rad, Hercules, CA, USA), which measures the ratio of target protein to total protein amounts based on gel band intensity. Bio-Rad protein assay reagent was used for quantitative analysis of total protein.
Purification of the Swollenin Protein
Culture supernatant was collected by filtration after 4 days of culture and precipitated by ammonia sulfate at 85% saturation. The precipitation was resuspended in 20 mM sodium acetate buffer (pH 4.0). The re-dissolved solution was dialyzed against 10 mM sodium acetate buffer (pH 4.4). The swollenin protein was then purified by cationic exchange chromatography. All the purification operations were performed on the AKTA purifier system (Amersham Phamacia) with CM-Sepharose as the media for cationic exchange chromatography. The column (XK 16 Phamacia) was equilibrated with binding buffer (10 mM sodium acetate, pH 4.4), followed with sample loading and equilibration. The flowrate of the protein was 0.5 mL min−1. After washing with three bed volume binding buffer, the bound protein was eluted by the elution buffer (10 mM sodium acetate, 0.6 M NaCl, pH 4.4). The elute was collected for SDS-PADE analysis.
Enzymatic Hydrolysis Activity Assay of Cellulose
Cellulose hydrolysis was conducted in test tubes. The filter paper (Xinhua, Hangzhou, China) was cut into 1 × 2 cm strips (16 mg each) as a substrate for cellulose hydrolysis.
The activity of cultural supernatants was measured as follows: the filter paper was suspended in 2 mL 50 mM sodium acetate buffer (pH 4.8). Added into the reaction system were 0.5 mL supernatant from the culture medium and 0.5 mL commercial cellulase (0.15 FPU cellulase g−1 filter paper). Used as control was 50 mM sodium acetate buffer (pH 4.8). The enzymatic hydrolysis reaction was conducted at 50°C for 12 h.
The activity of purified swollenin was measured as follows: the filter paper was suspended in 2 mL 50 mM sodium acetate buffer (pH 4.8). Added into the reaction system were 0.5 mL purified swollenin (the final concentration of 0–300 μg protein g−1 filter paper) and 0.5 mL commercial cellulase (the final concentration was 0.06 FPU cellulase g−1 filter paper). The bovine serum albumin (BSA) was used as control. The test tubes were then plugged and incubated in an incubator at 50°C. Triplicate samples were evaluated every 12 h to assay the reducing sugar levels.
The amount of reducing sugars was determined by using dinitrosalicylic acid reagent [17]. The absorbance at 540 nm was measured and compared to a standard curve of glucose to determine the concentration of reducing sugars. Triplicate data were expressed as the mean ± the standard deviation.
The synergistic activity is calculated as following:
A indicates reducing sugar released by swollenin and cellulase and B indicates reducing sugar released by cellulase alone.
Results and Discussion
Expression of Swollenin in Recombinant A. oryzae
According to SDS-PAGE analysis, the recombinant swollenin was successfully expressed in A. oryzae. The target protein was around 75 kDa as shown in Fig. 1, whereas the calculated molecular mass of the swollenin is only 51 kDa. The result was similar to the previous report [6, 15]. The probable reason cause the difference between the calculated and observed molecular masses is the existence of glycosylation (including N-glycosylation and O-glycosylation) and other modification sites[6, 18]. The synergistic activity of the cultural supernatant and cellulase was show in Table 1. The swollenin cannot hydrolyze the filter paper and produce reducing sugar by itself, which is accordant with former study [6].
Effects of Carbon Source on Swollenin Expression
As one of the major medium compositions, carbon source is essential to support both cell growth and recombinant protein expression. The strain was cultured using eight different carbon sources: glucose, galactose, maltose, fucose, sucrose, dextrin, soluble starch, and glycerin. The fermentation cultivation was carried out for 96 h and the synergistic activity of the swollenin was calculated. As shown in Fig. 2, glycerin and sucrose were more efficient as carbon source than the others for higher swollenin activity. The maximum synergistic activity of swollenin (31.3%) was observed when glycerin served as the carbon source. Glycerin was employed for subsequent experiments.
The effect of the amount of the glycerin (10−1, 20−1, 30−1, 40−1, 50−1, and 60 g L−1) indicates that 20 g L−1 is the optimal amount for swollenin activity, while the synergistic activity value of the cultural supernatant reached 38.7%. As the concentration of carbon sources increased, the dry cell weight increased and the terminal pH decreased, the maximum cell growth was achieved at the glycerin amount of 60 g L−1 (Fig. 3).
Effects of Nitrogen Source on Swollenin Expression
Eight different nitrogen sources including polypeptone, yeast extract, corn flour, corn gluten meal, peanut meal, fish meal, (NH4)2SO4 and the mixture of polypeptone and yeast extract were tested for swollenin production at the concentration of 15 g L−1, respectively. As shown in Fig. 4, the optimal nitrogen source for swollenin activity is peanut meal and the synergistic activity is 43.9%. The mixture of polypeptone and yeast extract is alternatively choice for nitrogen source, while the synergistic activity was 40.7%. When (NH4)2SO4 served as the nitrogen source, the dry cell weight is the lowest and the synergistic activity cannot be detected, which indicates that organic compounds are more efficient than inorganic compounds for swollenin production. Thus, the peanut meal was adopted as nitrogen source in the succeeding experiments.
Effects of different nitrogen sources on swollenin activity and cell growth. Experiments were performed in triplicate, and the heights of the bars and the error bars indicate the means ± standard deviations; 1 corn gluten meal, 2 corn flour, 3 yeast extract, 4 the mixture of polypeptone and yeast extract, 5 peanut meal, 6 polypeptone, 7 fish meal, 8 (NH4)2SO4
Effects of Fermentation Time on Swollenin Expression
The optimal fermentation time was determined by analyzing samples taken at every 8 h till 120 h. The SDS-PAGE and the synergistic activity of soluble protein were shown in Fig. 5. The concentration of target protein is not proportional to the expression time (Fig. 5a). The swollenin expressed can be detected by SDS-PAGE at 56 h and the maximum swollenin yield was achieved at 88 h. Overtime fermentation results in lower swollenin yield. Synergistic activity assays (Fig. 5b) showed the similar tendency compare to the swollenin yield change over time. The synergistic activity of soluble protein reached the maximum of 44.8% after fermentation for 88 h.
a SDS-PAGE analysis of proteins of different cultivation time from the recombinant Aspergillus oryzae. M protein molecular weight markers; 1 8 h, 2 16 h, 3 24 h, 4 32 h, 5 40 h, 6 48 h, 7 56 h, 8 64 h, 9 72 h, 10 80 h, 11 88 h, 12 96 h, 13 104 h, 14 112 h, 15 120 h. b Effects of fermentation cultivation time on swollenin activity
Effects of pH Value on Swollenin Expression
The effect of pH of the fermentation medium on swollenin synergistic activity was investigated. The pH was regulated to 4.8, 5.2, 5.6, 6.0, 6.4, and 6.8 by HCl or NaOH, respectively. As shown in Fig. 6, the swollenin synergistic activity reached its highest value of 58.2% at pH 5.6. The cultivation pH has been shown to be of particular importance in respect of some enzymes production by A. oryzae [19]; the result here indicates that pH 5.6 is the optimal pH value for swollenin production.
Efficient Purification of Swollenin
The recombinant swollenin protein was purified to near homogeneity from the cultural supernatant by ammonium sulfate precipitation and cationic exchange chromatography. Following the ammonium sulfate precipitation step, swollenin protein purity increased from 3.6% to 4.5% with 75.8% product recovery. Purity of swollenin increased from 4.5% to 95.1% in the step of cationic exchange chromatography (Fig. 7). Quantitative protein analysis revealed that swollenin recovery was 70.2% after the cationic exchange step. The overall recovery of swollenin in the process reported in this work was 53.2% and 26.6 mg swollenin was purified from 1 L fermentation medium finally.
Synergistic Effect of the Purified Swollenin on Cellulose Hydrolysis with Cellulase
The synergistic activity of the purified swollenin was tested. The relationship between the synergistic effect and the amount of the purified swollenin added is shown in Table 2. Reaction system was composed of different concentrations of swollenin (0, 100, 200, or 300 μg) and 0.06 FPU of cellulase g−1 filter paper. BSA was added in the reaction system and served as a negative control. As the concentration of swollenin increased, the synergistic activity increased. When 100, 200, and 300 μg of swollenin g−1 filter paper was used, the amount of released reducing sugar after 36 h was 44.4%, 59.6%, and 81.7% higher than that of control, respectively.
Conclusions
The recombinant swollenin was successfully expressed in A. oryzae. In order to improve the activity of the protein, the effects of different medium composition and expression conditions were investigated and the optimal conditions were determined as follows: cultivation in the medium with glycerin and peanut as the carbon and nitrogen source, respectively, at pH 5.6, and expression for 88 h. The swollenin was then successfully purified from the cultural supernatant by ammonium sulfate precipitation and cationic exchange chromatography. The purity and overall recovery of the swollenin was 95.1% and 53.2% after purification, respectively. 26.6 mg swollenin could be purified from 1 L fermentation medium. Finally, the assays of synergistic activity of the purified swollenin were performed. The purified swollenin exhibited a significant synergistic effect on cellulose hydrolysis with cellulase. When a mixture containing 0.6 FPU cellulase and 300 μg of swollenin g−1 filter paper was evaluated, the released reducing sugar yield was 81.7% higher than that of control. This work would be helpful to large-scale production of this important enzyme for the dissolution and regeneration of cellulose.
References
McQueen-Mason, S., Durachko, D. M., & Cosgrove, D. J. (1992). 2 endogenous proteins that induce cell wall extension in plants. Plant Cell, 4(11), 1425–1433.
Cosgrove, D. J. (2000). Loosening of plant cell walls by expansins. Nature, 407(6802), 321–326.
McQueen-Mason, S., & Cosgrove, D. J. (1994). Disruption of hydrogen-bonding between plant-cell wall polymers by proteins that induce wall extension. Proceedings of the National Academy of Sciences of the United States of America, 91(14), 6574–6578.
Whitney, S. E. C., Gidley, M. J., & McQueen-Mason, S. J. (2000). Probing expansin action using cellulose/hemicellulose composites. Plant Journal, 22(4), 327–334.
Li, Y., Jones, L., & McQueen-Mason, S. (2003). Expansins and cell growth. Current Opinion in Plant Biology, 6(6), 603–610.
Saloheimo, M., et al. (2002). Swollenin, a Trichoderma reesei protein with sequence similarity to the plant expansins, exhibits disruption activity on cellulosic materials. European Journal of Biochemistry, 269(17), 4202–4211.
Lynd, L. C., Cushman, J. H., Nichols, R. J., et al. (1991). Fuel ethanol from cellulosic biomass. Science, 251(4999), 1318–1323.
Gregg, D. J., Boussaid, A., & Saddler, J. N. (1998). Techno-economic evaluations of a generic wood-to-ethanol process: effect of increased cellulose yields and enzyme recycle. Bioresource Technology, 63(1), 7–12.
Wingren, A., Galbe, M., & Zacchi, G. (2003). Techno-economic evaluation of producing ethanol from softwood: comparison of SSF and SHF and identification of bottlenecks. Biotechnology Progress, 19(4), 1109–1117.
Jiang, L., et al. (2010). Phosphoenolpyruvate-dependent phosphorylation of sucrose by Clostridium tyrobutyricum ZJU 8235: evidence for the phosphotransferase transport system. Bioresource Technology, 101(1), 304–309.
Jiang, L., et al. (2009). Butyric acid fermentation in a fibrous bed bioreactor with immobilized Clostridium tyrobutyricum from cane molasses. Bioresource Technology, 100(13), 3403–3409.
Shi, F., Xu, Z. N., & Cen, P. L. (2006). Optimization of gamma-polyglutamic acid production by Bacillus subtilis ZJU-7 using a surface-response methodology. Biotechnology and Bioprocess Engineering, 11(3), 251–257.
Shi, F., Xu, Z. N., & Cen, P. L. (2006). Efficient production of poly-gamma-glutamic acid by Bacillus subtilis ZJU-7. Applied Biochemistry and Biotechnology, 133(3), 271–281.
Levasseur, A., et al. (2006). Production of a chimeric enzyme tool associating the Trichoderma reesei swollenin with the Aspergillus niger feruloyl esterase A for release of ferulic acid. Applied Microbiology and Biotechnology, 73(4), 872–880.
Yao, Q., et al. (2008). Gene cloning and heterologous expression of a novel endoglucanase, swollenin, from Trichoderma pseudokoningii S38. Bioscience Biotechnology and Biochemistry, 72(11), 2799–2805.
Laemmli, U. K. (1970). Cleavage of structural proteins during the assembly of the head of bacteriophage T4. Nature, 227(5259), 680–685.
Zhong, Y. X., et al. (2008). Expansin and XET genes are differentially expressed during aril breakdown in harvested longan fruit. Journal of the American Society for Horticultural Science, 133(3), 462–467.
Fagerstam, L. P., Pettersson, L. G., & Engstrom, J. A. (1984). The primary structure of a 1,4-beta-glucan cellobiohydrolase from the fungus Trichoderma reesei QM-9414. FEBS Letters, 167(2), 309–315.
Chipeta, Z., du Preez, J. C., & Christopher, L. (2008). Effect of cultivation pH and agitation rate on growth and xylanase production by Aspergillus oryzae in spent sulphite liquor. Journal of Industrial Microbiology and Biotechnology, 35(6), 587–594.
Acknowledgments
This work was financially supported by the National High Technology Research and Development Program of China (2009AA02Z206), the National Basic Research Program of China (2007CB707805), and Nature Science Foundation of China (20736008, 20676115).
Author information
Authors and Affiliations
Corresponding authors
Rights and permissions
About this article
Cite this article
Wang, M., Cai, J., Huang, L. et al. High-Level Expression and Efficient Purification of Bioactive Swollenin in Aspergillus oryzae . Appl Biochem Biotechnol 162, 2027–2036 (2010). https://doi.org/10.1007/s12010-010-8978-0
Received:
Accepted:
Published:
Issue Date:
DOI: https://doi.org/10.1007/s12010-010-8978-0